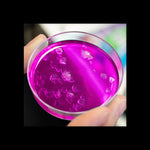

Product
Unicorn Scientist
Regular price 16.990 JD
In Stock
80002659
-
 Free shipping orders above 50 JD
Free shipping orders above 50 JD -
 100% safe for kids
100% safe for kids -
 Free wrapping & gift
Free wrapping & gift -
 Returns within 7 days
Returns within 7 days
Science and imagination together can create wonders!Discover the magical world of unicorns and let your imagination and science come together to make the most amazing experiments. With this kit you can Make an incredible unicorn horn and sparkly eggs, create different colored crystals, make crystallized messages, and many more experiments!-Includes: Science kit with 19 contents for 10 experiments, and educational book.